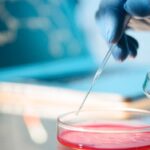

UFC President Dana White recently made headlines with his bold claim that the Power Slap League (PSL) has achieved unparalleled social media popularity, surpassing even the most established sports leagues. In a statement that has sparked discussions across the sports world, White highlighted the meteoric rise of the PSL and its impact on the digital landscape.
White pointed to the PSL’s innovative format, which features intense one-on-one competitions where participants deliver powerful slaps to each other’s faces. This unique and attention-grabbing concept has resonated with audiences worldwide, driving a surge in social media engagement and viewership numbers.
According to White, the PSL’s success on social media platforms such as Instagram, TikTok, and YouTube has been nothing short of remarkable. The league’s videos showcasing jaw-dropping slap exchanges have gone viral, attracting millions of views and generating widespread discussion and debate.
White also emphasized the PSL’s ability to connect with younger demographics, citing its appeal to a generation that craves fast-paced, adrenaline-fueled content. The league’s emphasis on raw power and physicality has struck a chord with viewers who are seeking thrilling and unconventional sports experiences.
The UFC President’s comments shed light on the evolving landscape of sports entertainment and the growing influence of digital platforms. As traditional sports leagues continue to adapt to the digital age, the success of ventures like the PSL serves as a testament to the power of engaging content and creative storytelling.
It’s worth noting that while the PSL’s social media popularity is undeniable, its long-term sustainability and mainstream appeal remain subjects of debate. Critics argue that the novelty of slap-based competitions may wear off over time, raising questions about the league’s ability to maintain its current level of engagement.
Nevertheless, White’s endorsement of the PSL as a social media juggernaut underscores the shifting dynamics in the sports industry. As digital platforms continue to shape how sports are consumed and experienced, leagues and organizations are exploring new avenues to capture audience attention and engagement.
In conclusion, Dana White’s assertion regarding the Power Slap League’s social media dominance reflects a broader trend of sports innovation and digital disruption. While the PSL’s rise may be unconventional, its impact on social media and sports culture serves as a compelling example of the changing dynamics in the global sports landscape.